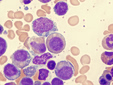
Μυελοδυσπλαστικά Σύνδρομα: Παθοφυσιολογία, διάγνωση και θεραπευτικές προσεγγίσεις

Ειδήσεις
Μήπως η “μύτη” σας δεν είναι αρκετά ερωτική;
Λονδίνο: Οι γυναίκες που χρησιμοποιούν αντισυλληπτικά χάπια ενδέχεται να μην αντιλαμβάνονται τις οσμές που τις κάνουν ακαταμάχητες στους άνδρες. Αυτό τουλάχιστον υποστηρίζουν ερευνητές από το Πανεπιστήμιο της Κατάνια σε μελέτη τους που δημοσιεύεται στην επιθεώρηση Human Reproduction.

Αριθμός Πιστοποίησης Μ.Η.Τ.232442
Αριθμός Πιστοποίησης Μ.Η.Τ.232442